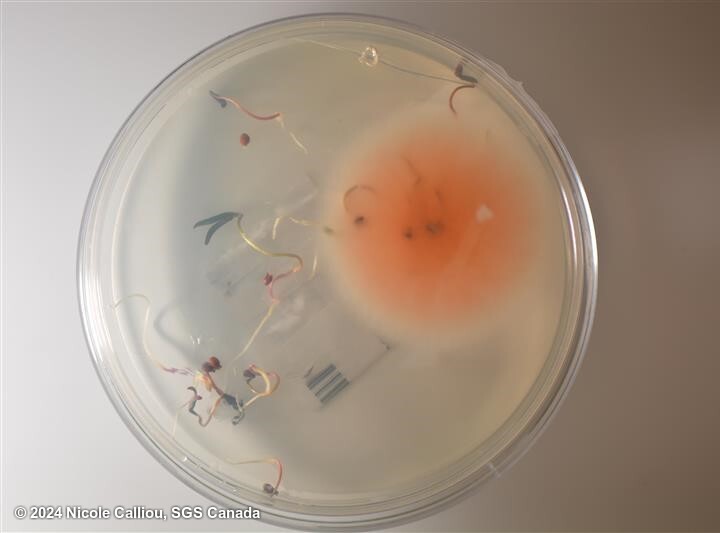
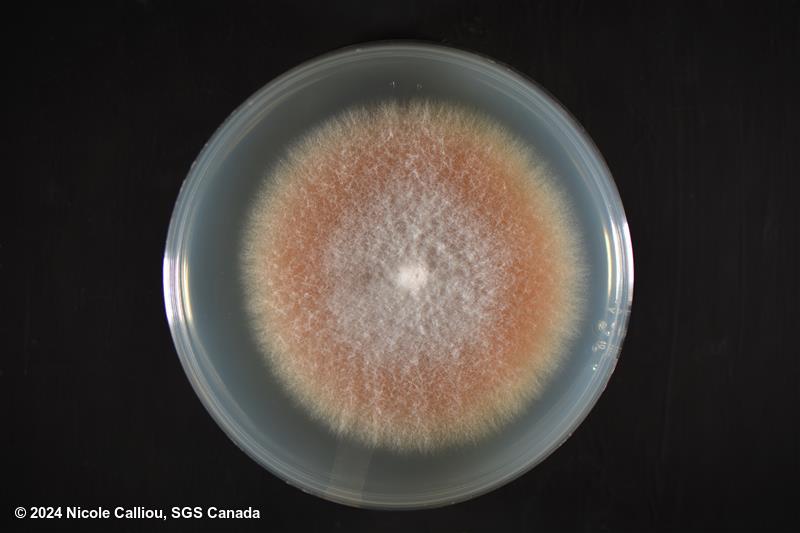
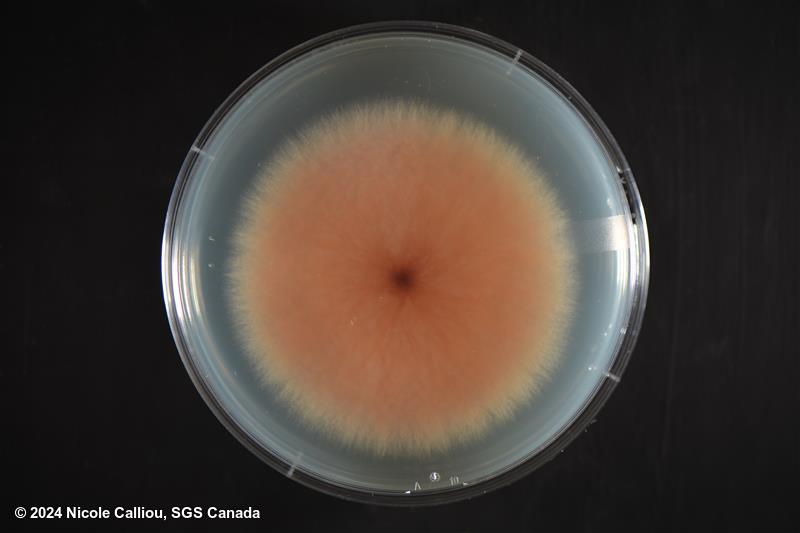

Submission
Fusarium oxysporum on Chenopodium quinoa
- Credits / Owner: Nicole Calliou, SGS Canada
- Submission date: 2024-06-28 17:21:37
- Submission ID: #58
Pathogen
|
Scientific name
|
Fusarium oxysporum |
|
Genus
|
Fusarium |
|
EPPO code
|
FUSAOX |
|
Common name
|
Basalm rot, Corm rot, Foot rot, Root rot, Seedling wilting, Wilt |
|
Synonyms
|
Cylindrophora albedinis |
|
Crop
|
Chenopodium quinoa |
Submission
Description
Fusarium oxysporum colony natural infection on quinoa crop. Subsequent single spore colony images from original colony grown for 7-10 days.
| Sterilant: | 1% NaOCl |
| Sterilant time: | 10 min |
| Growth time: | 5-7 days |
| Lighting: | sunlight and darkness (12hr rotation) |
| Agar: | PDA |
| Agar brand: | Neogen |
| Sample origin: | Canada |